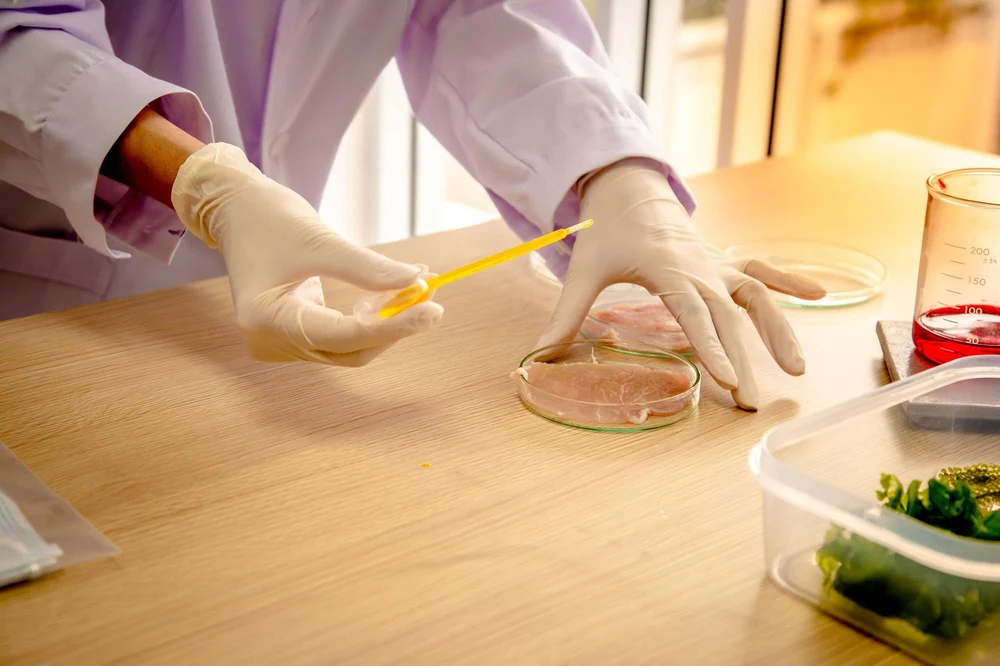

Testing Laboratory For Food Manufacturers
Our Experts Use the Latest Technology to Help
You Comply with FSSAI Regulations and Standards!

Our Experts Use the Latest Technology to Help
You Comply with FSSAI Regulations and Standards!

Our Experts Use the Latest Technology to Help
You Comply with FSSAI Regulations and Standards!
Equinox Labs (ISO 9001 Certified) is one of India’s leading FSSAI Certified and NABL Accredited Food, Water and Air Testing laboratory. With years of experience in Food Safety Audit for HoReCa, Manufacturing and Corporate sectors, we have always been a game-changer in Food Quality Testing, Water Testing, Air Testing and FSSAI Compliance. Equinox Labs provides complete safety and health services like Hygiene Audits & Food Testing in Mumbai, Hyderabad, Noida, Bengaluru and Chennai. With a dedicated team of over 550+ experts, we guarantee the best-in-class results for your products.
We also provide testing & auditing services to many other sectors, including Schools, Hospitals, Malls, Public Service Organizations, Travel Service Providers, etc.


Equinox Labs (ISO 9001 Certified) is one of India’s leading FSSAI Certified and NABL Accredited Food, Water and Air Testing laboratory. With years of experience in Food Safety Audit for HoReCa, Manufacturing and Corporate sectors, we have always been a game-changer in Food Quality Testing, Water Testing, Air Testing and FSSAI Compliance. Equinox Labs provides complete safety and health services like Hygiene Audits & Food Testing in Mumbai, Hyderabad, Noida, Bengaluru and Chennai. With a dedicated team of over 550+ experts, we guarantee the best-in-class results for your products.
We also provide testing & auditing services to many other sectors, including Schools, Hospitals, Malls, Public Service Organizations, Travel Service Providers, etc.
Our wide range of food testing services guarantees complete food safety, irrespective of the product’s complicated manufacturing process. Our services include:

Ensure your product stays fresh, safe, and tasty till its ‘Use By’ or ‘Best Before’ date.

Win consumer trust with accurate, easy-to-read nutrition facts on every pack.

Verify all label details to stay compliant and avoid regulatory penalties.

Keep your food products safe and hazard-free with rigorous chemical and biological testing.

Safeguard product quality by testing the water used in your food manufacturing process.

Know what your customers feel, taste and love—refine your product with expert sensory testing.
Our wide range of food testing services guarantees complete food safety, irrespective of the product’s complicated manufacturing process. Our services include:

Ensure your product stays fresh, safe, and tasty till its ‘Use By’ or ‘Best Before’ date.

Win consumer trust with accurate, easy-to-read nutrition facts on every pack.

Verify all label details to stay compliant and avoid regulatory penalties.

Keep your food products safe and hazard-free with rigorous chemical and biological testing.

Safeguard product quality by testing the water used in your food manufacturing process.

Know what your customers feel, taste and love—refine your product with expert sensory testing.
From packaged foods and beverages to water and raw ingredients, we test it all to ensure safety, compliance and quality at every step.












From packaged foods and beverages to water and raw ingredients, we test it all to ensure safety, compliance and quality at every step.












Get expert insights and practical tips in our free guide—designed to help you stay compliant and confidently grow your brand.
Learn the step-by-step process to accurately determine your product’s shelf life and ensure safety, quality and compliance.
Download Free Guide
Trusted by brands, we combine scientific expertise, quick turnaround and end-to-end support to keep your products safe and compliant.






Trusted by brands, we combine scientific expertise, quick turnaround and end-to-end support to keep your products safe and compliant.






We're always on the lookout to work with new clients. If you're interested in working with us, please get in touch in one of the following ways.
Let our food testing experts help you!